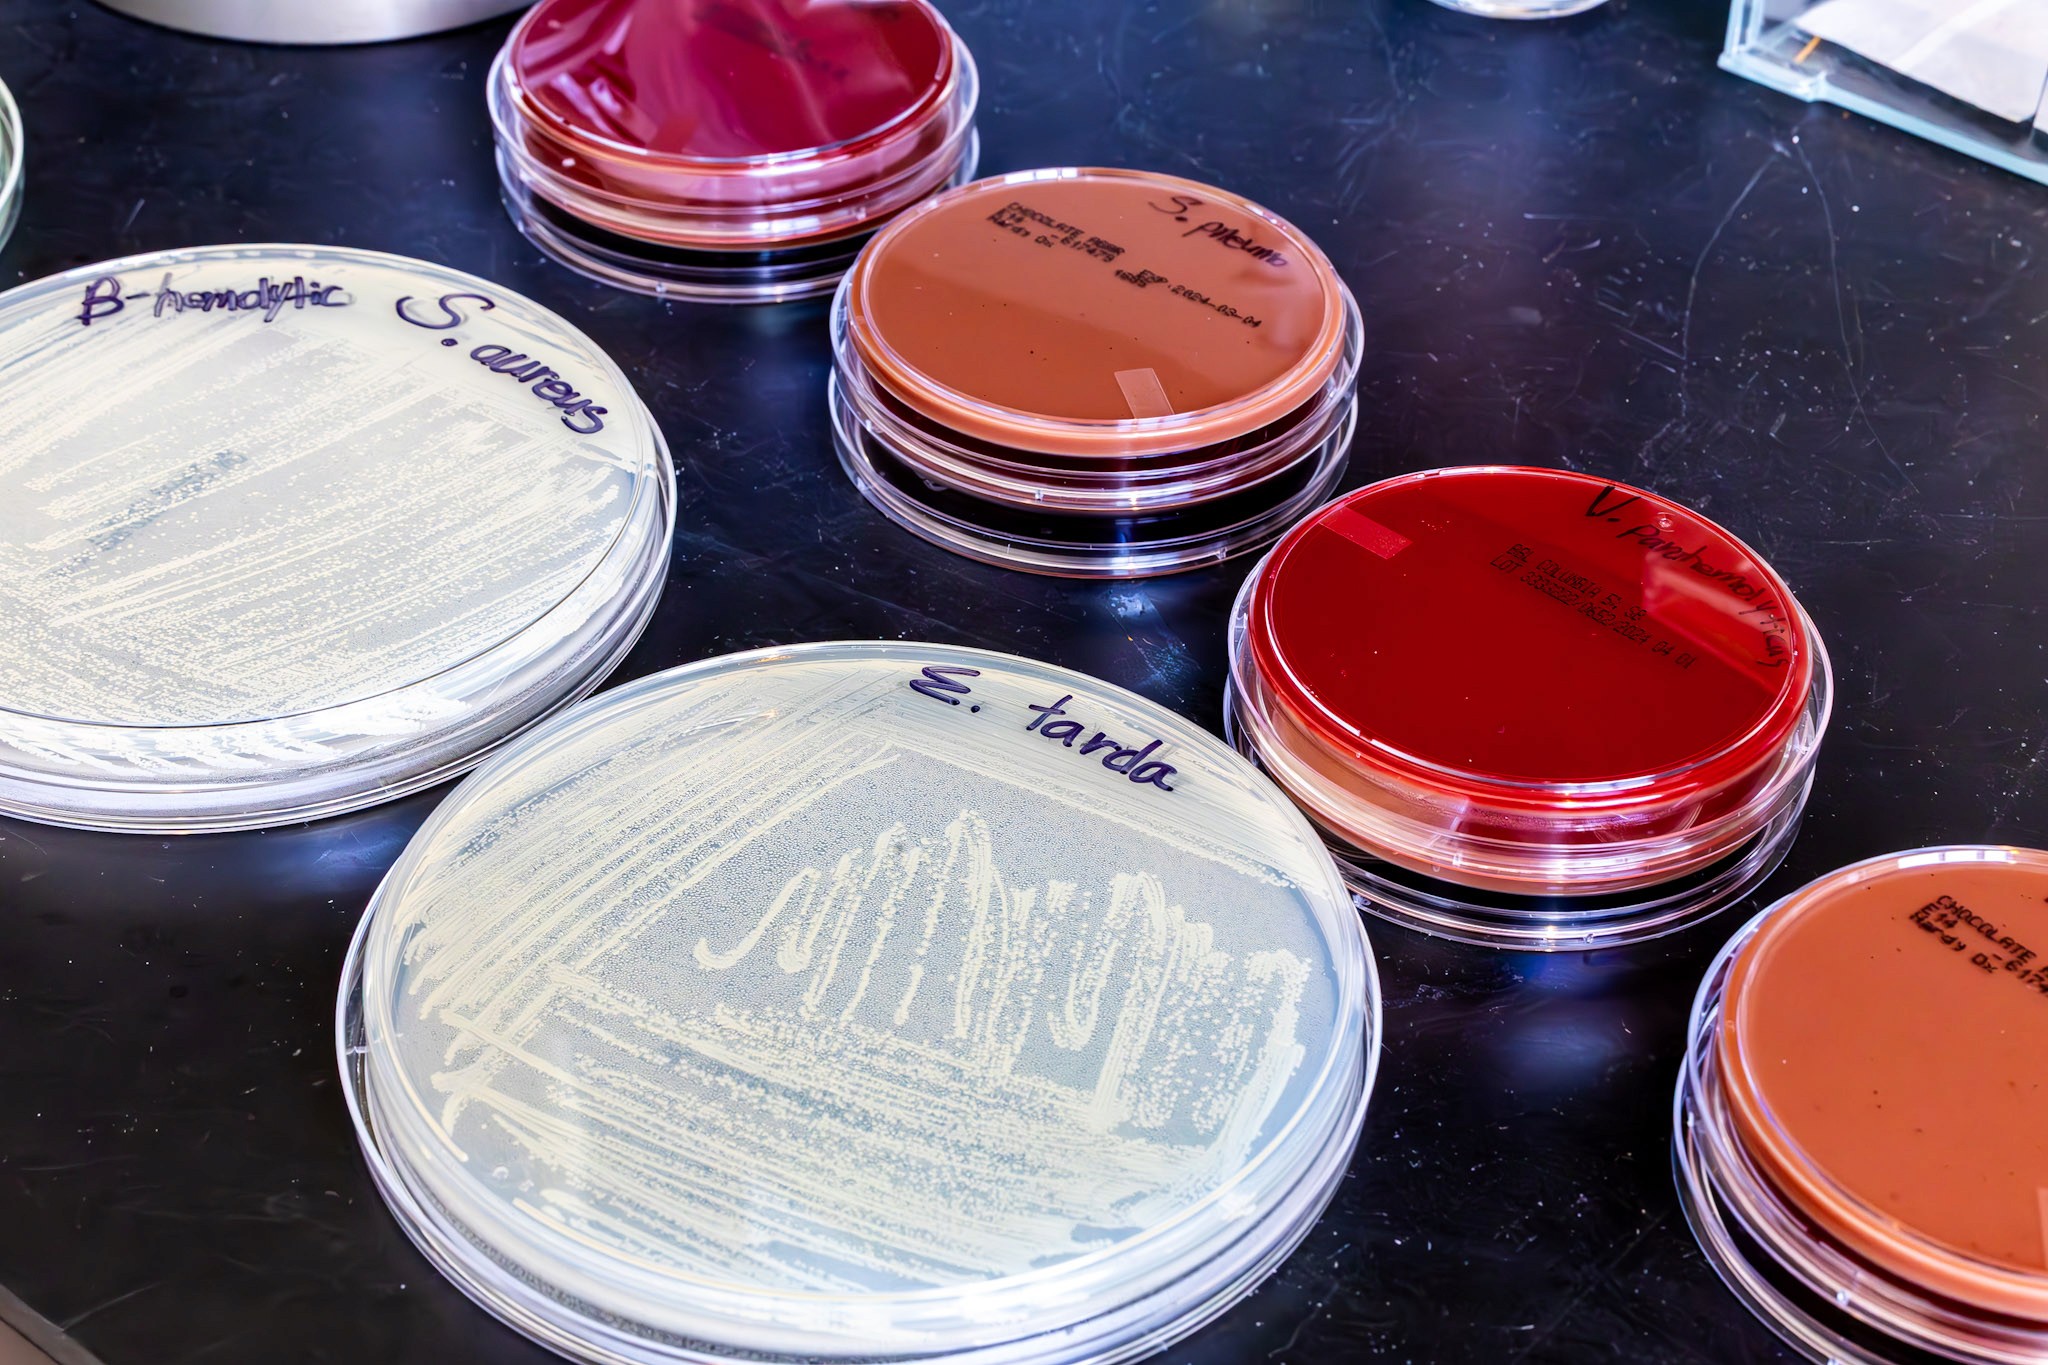
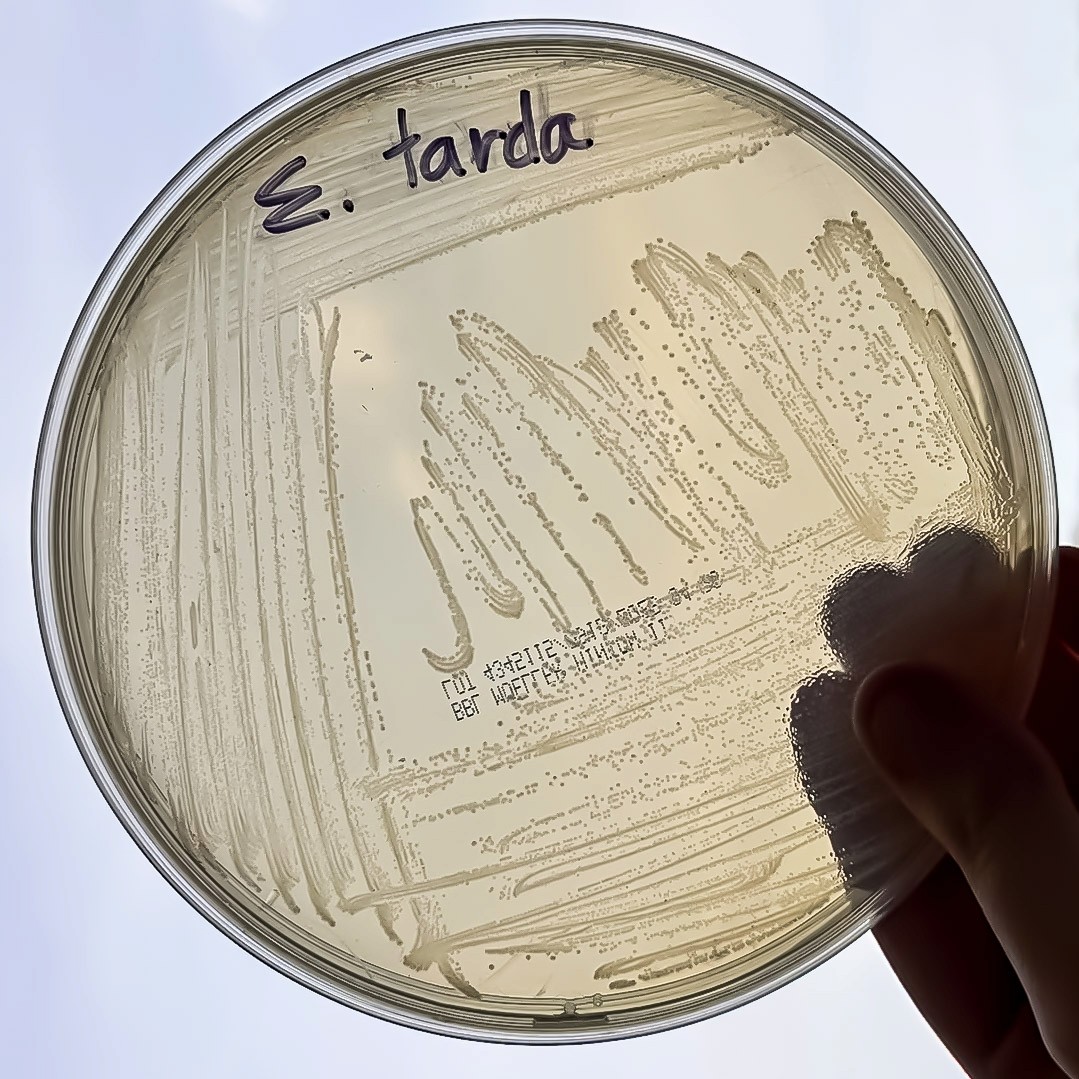
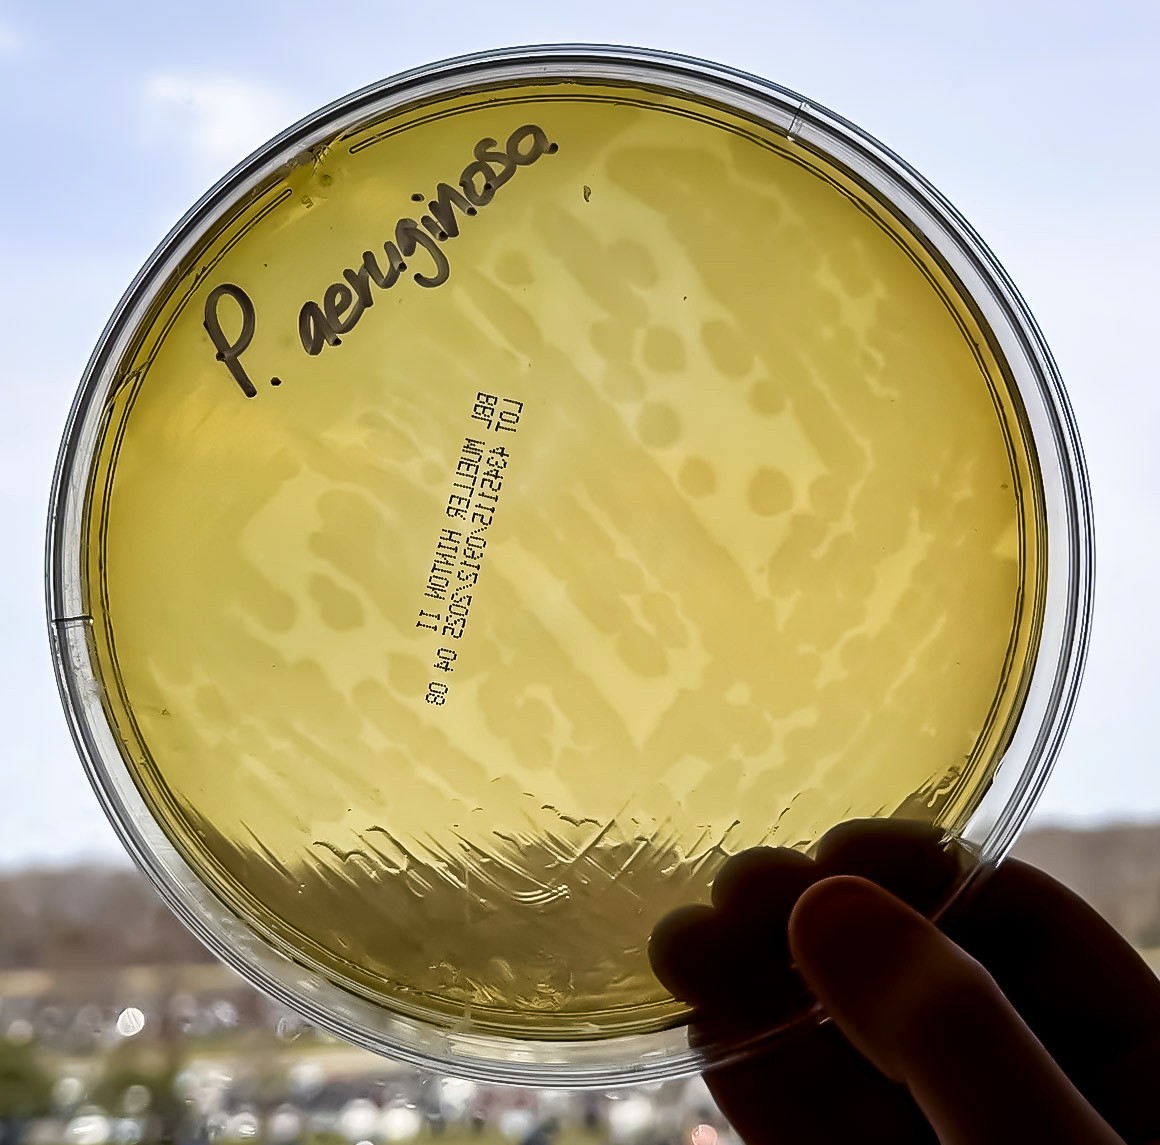
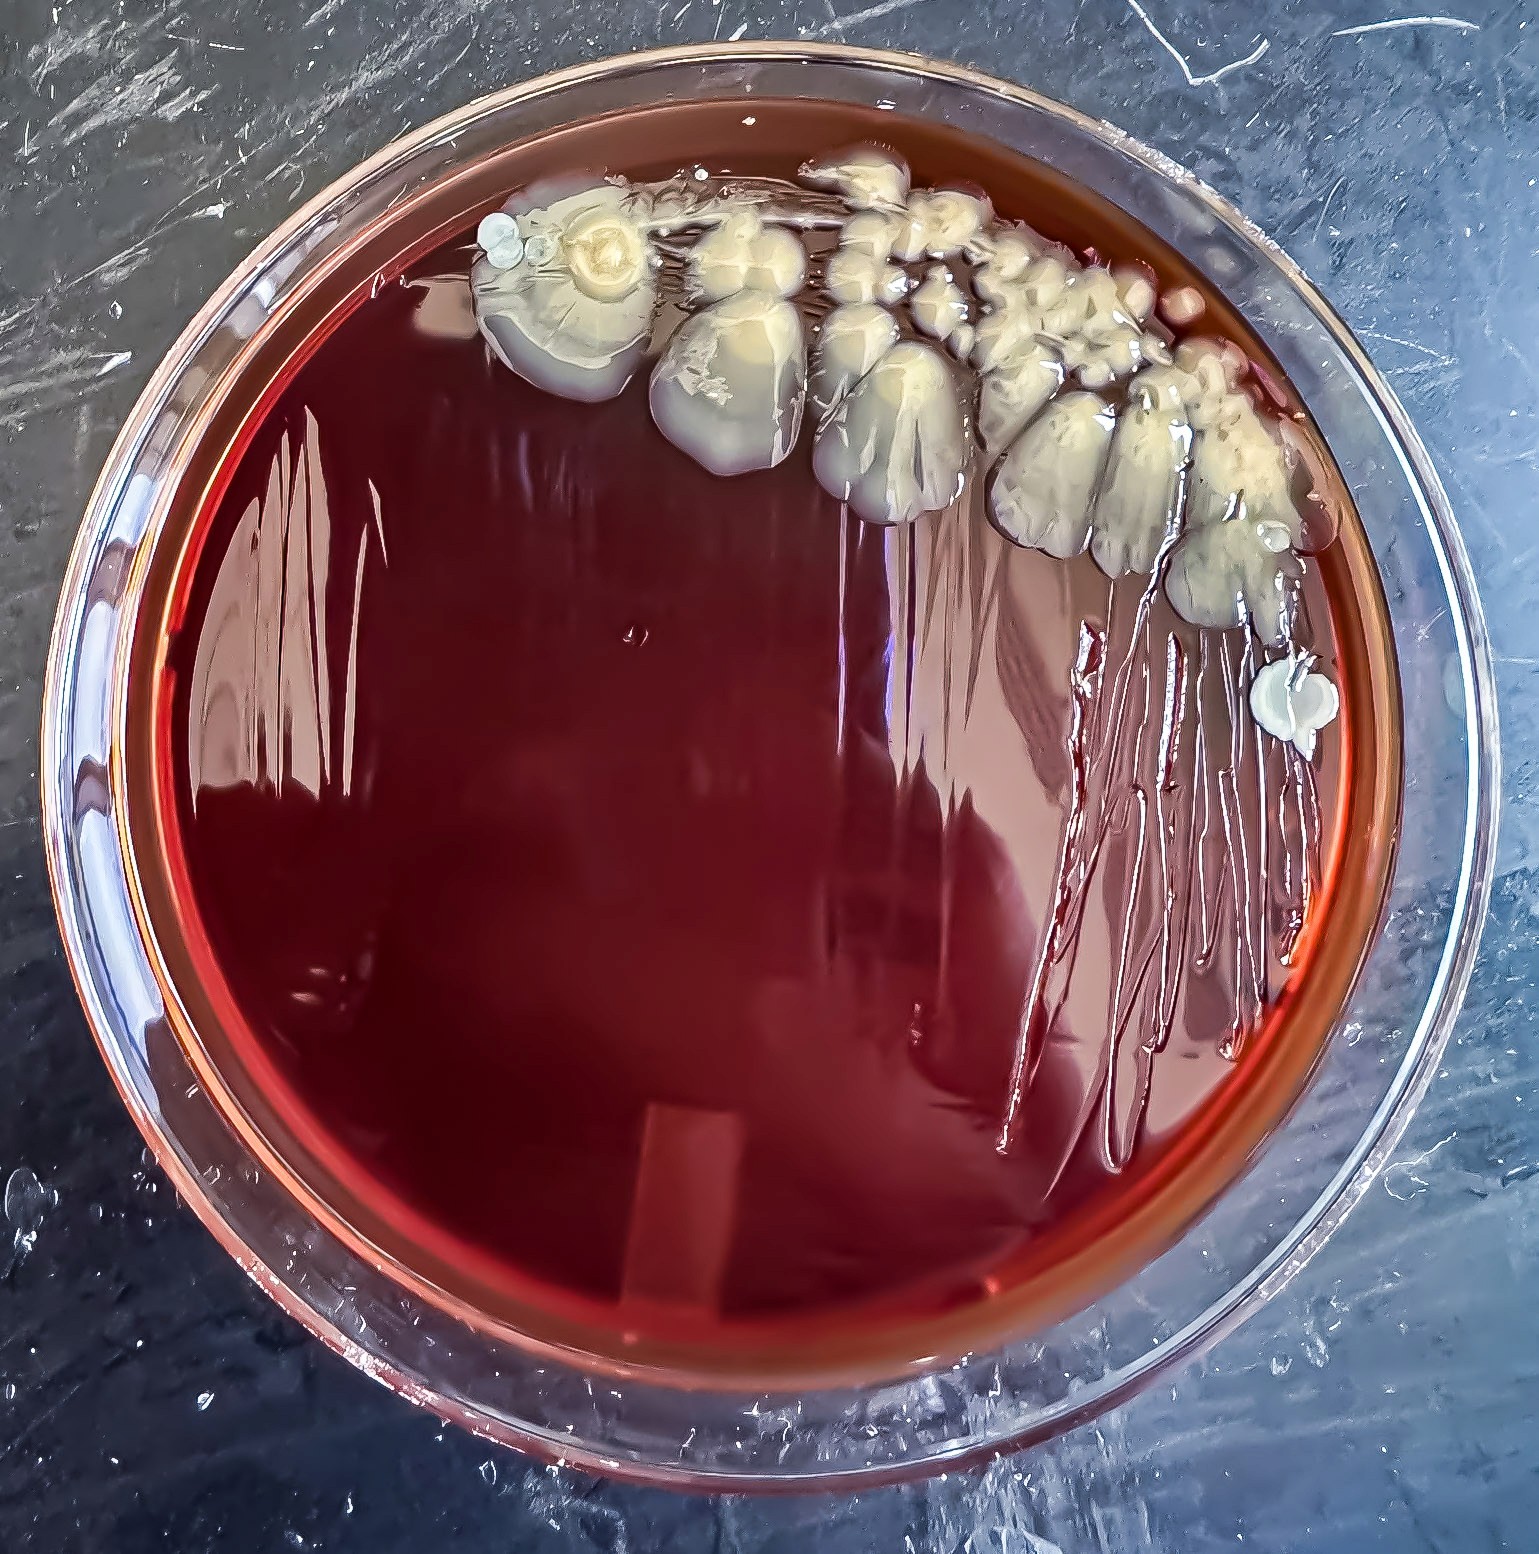
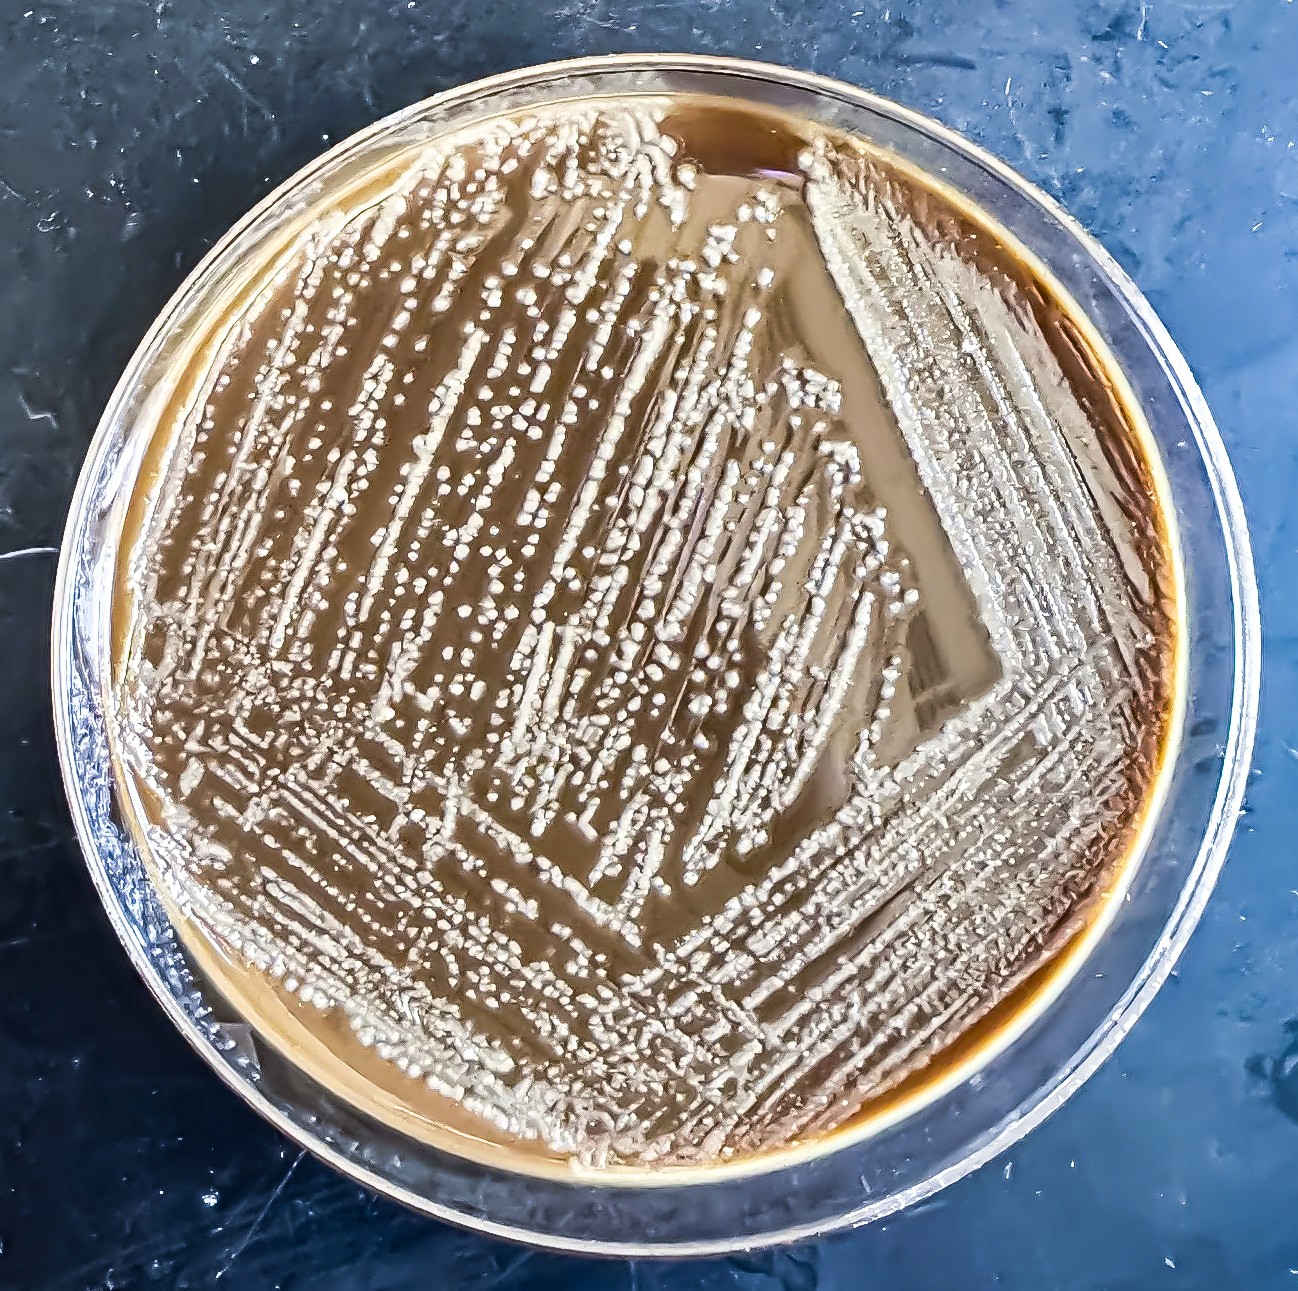
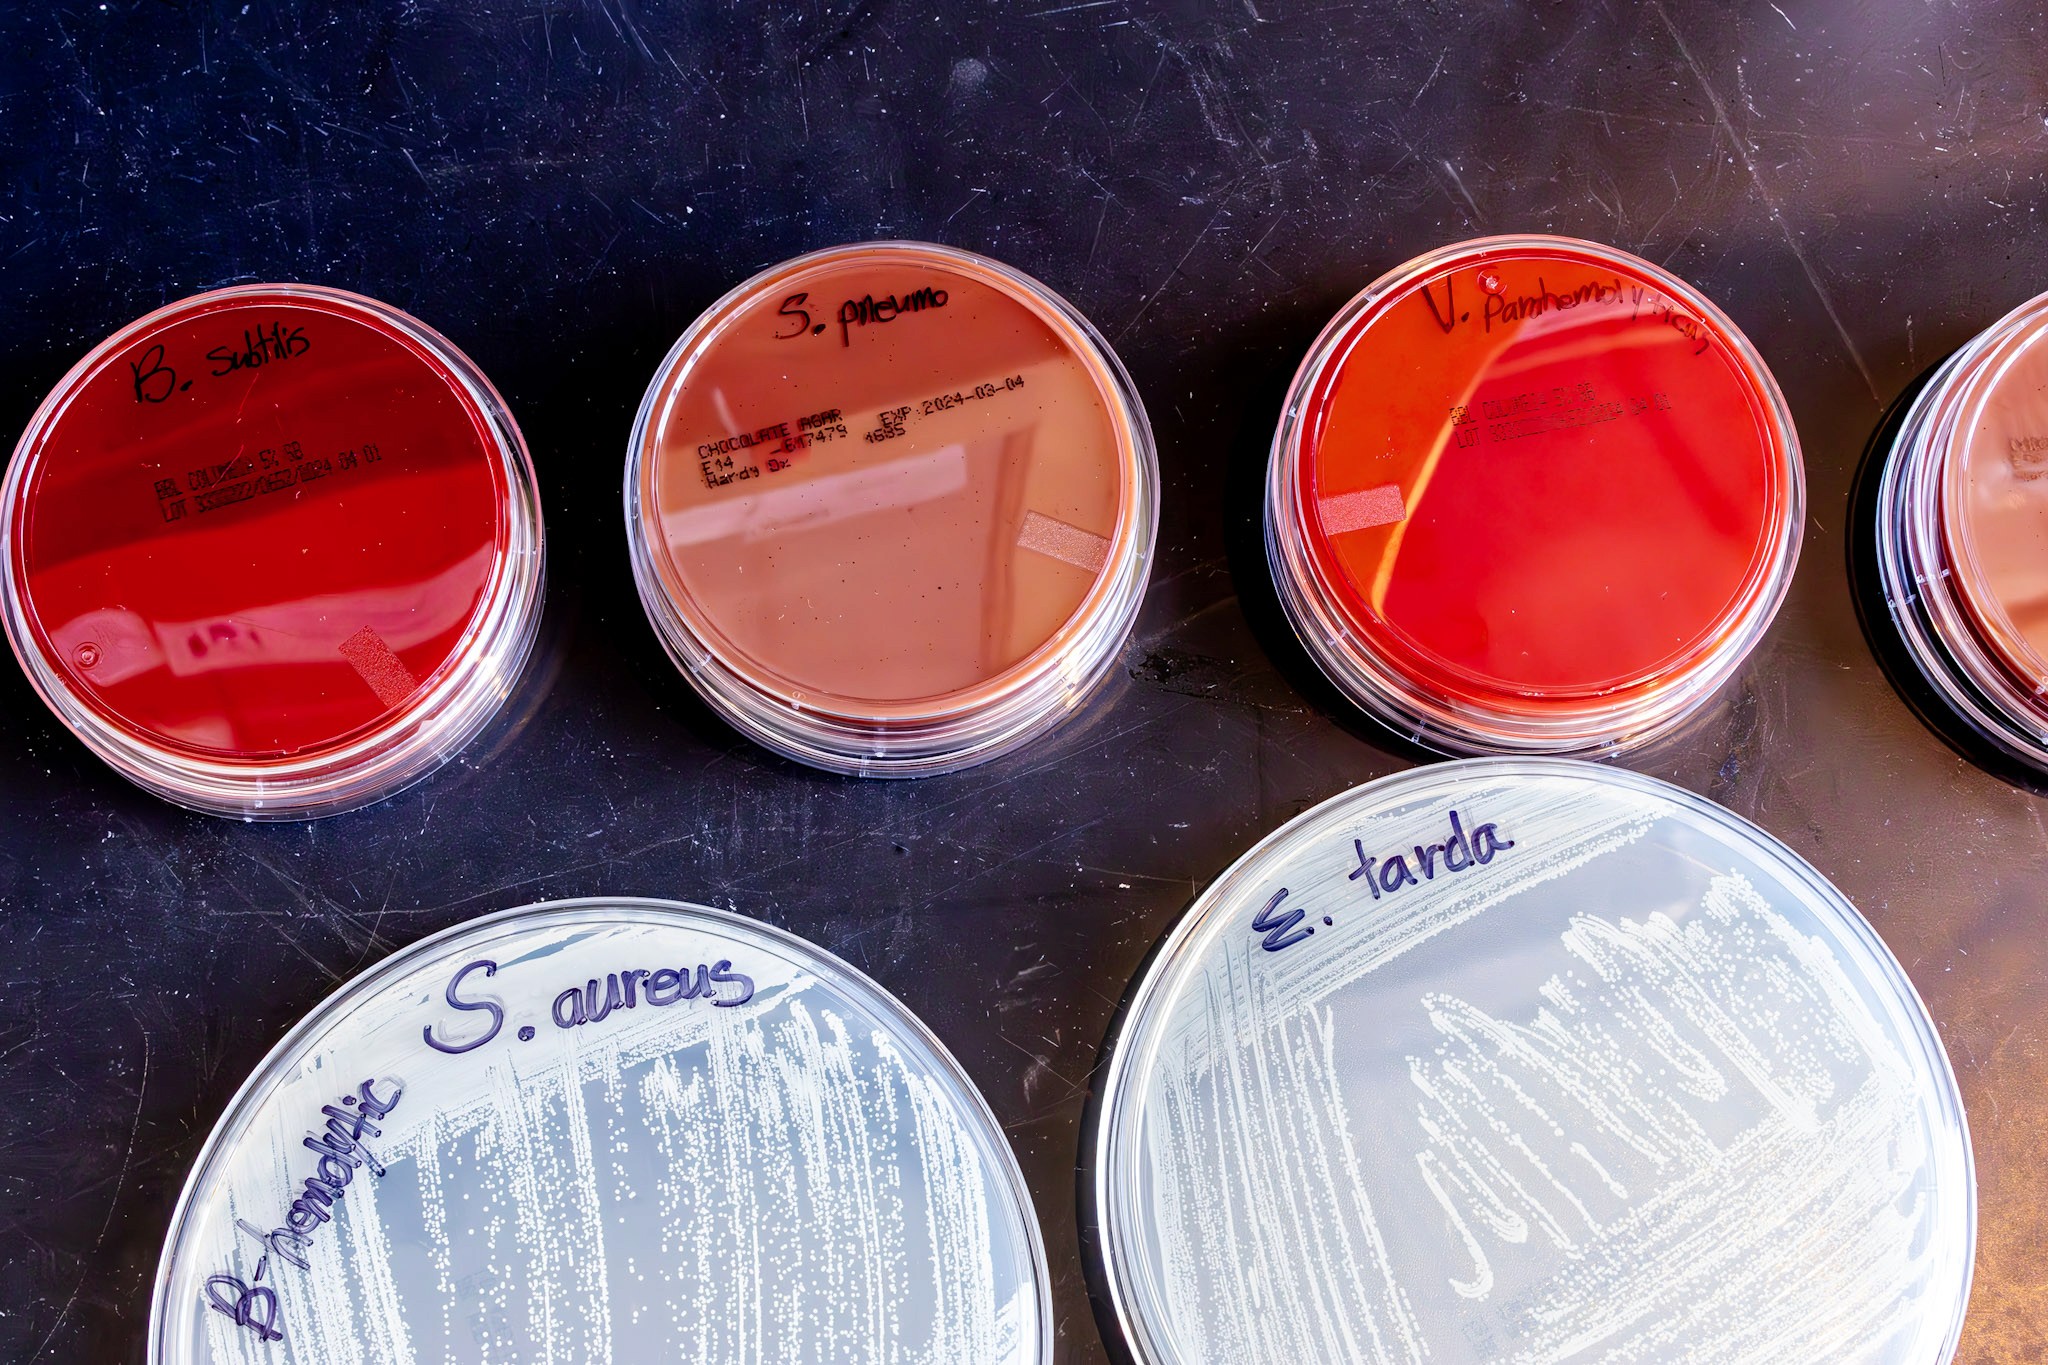
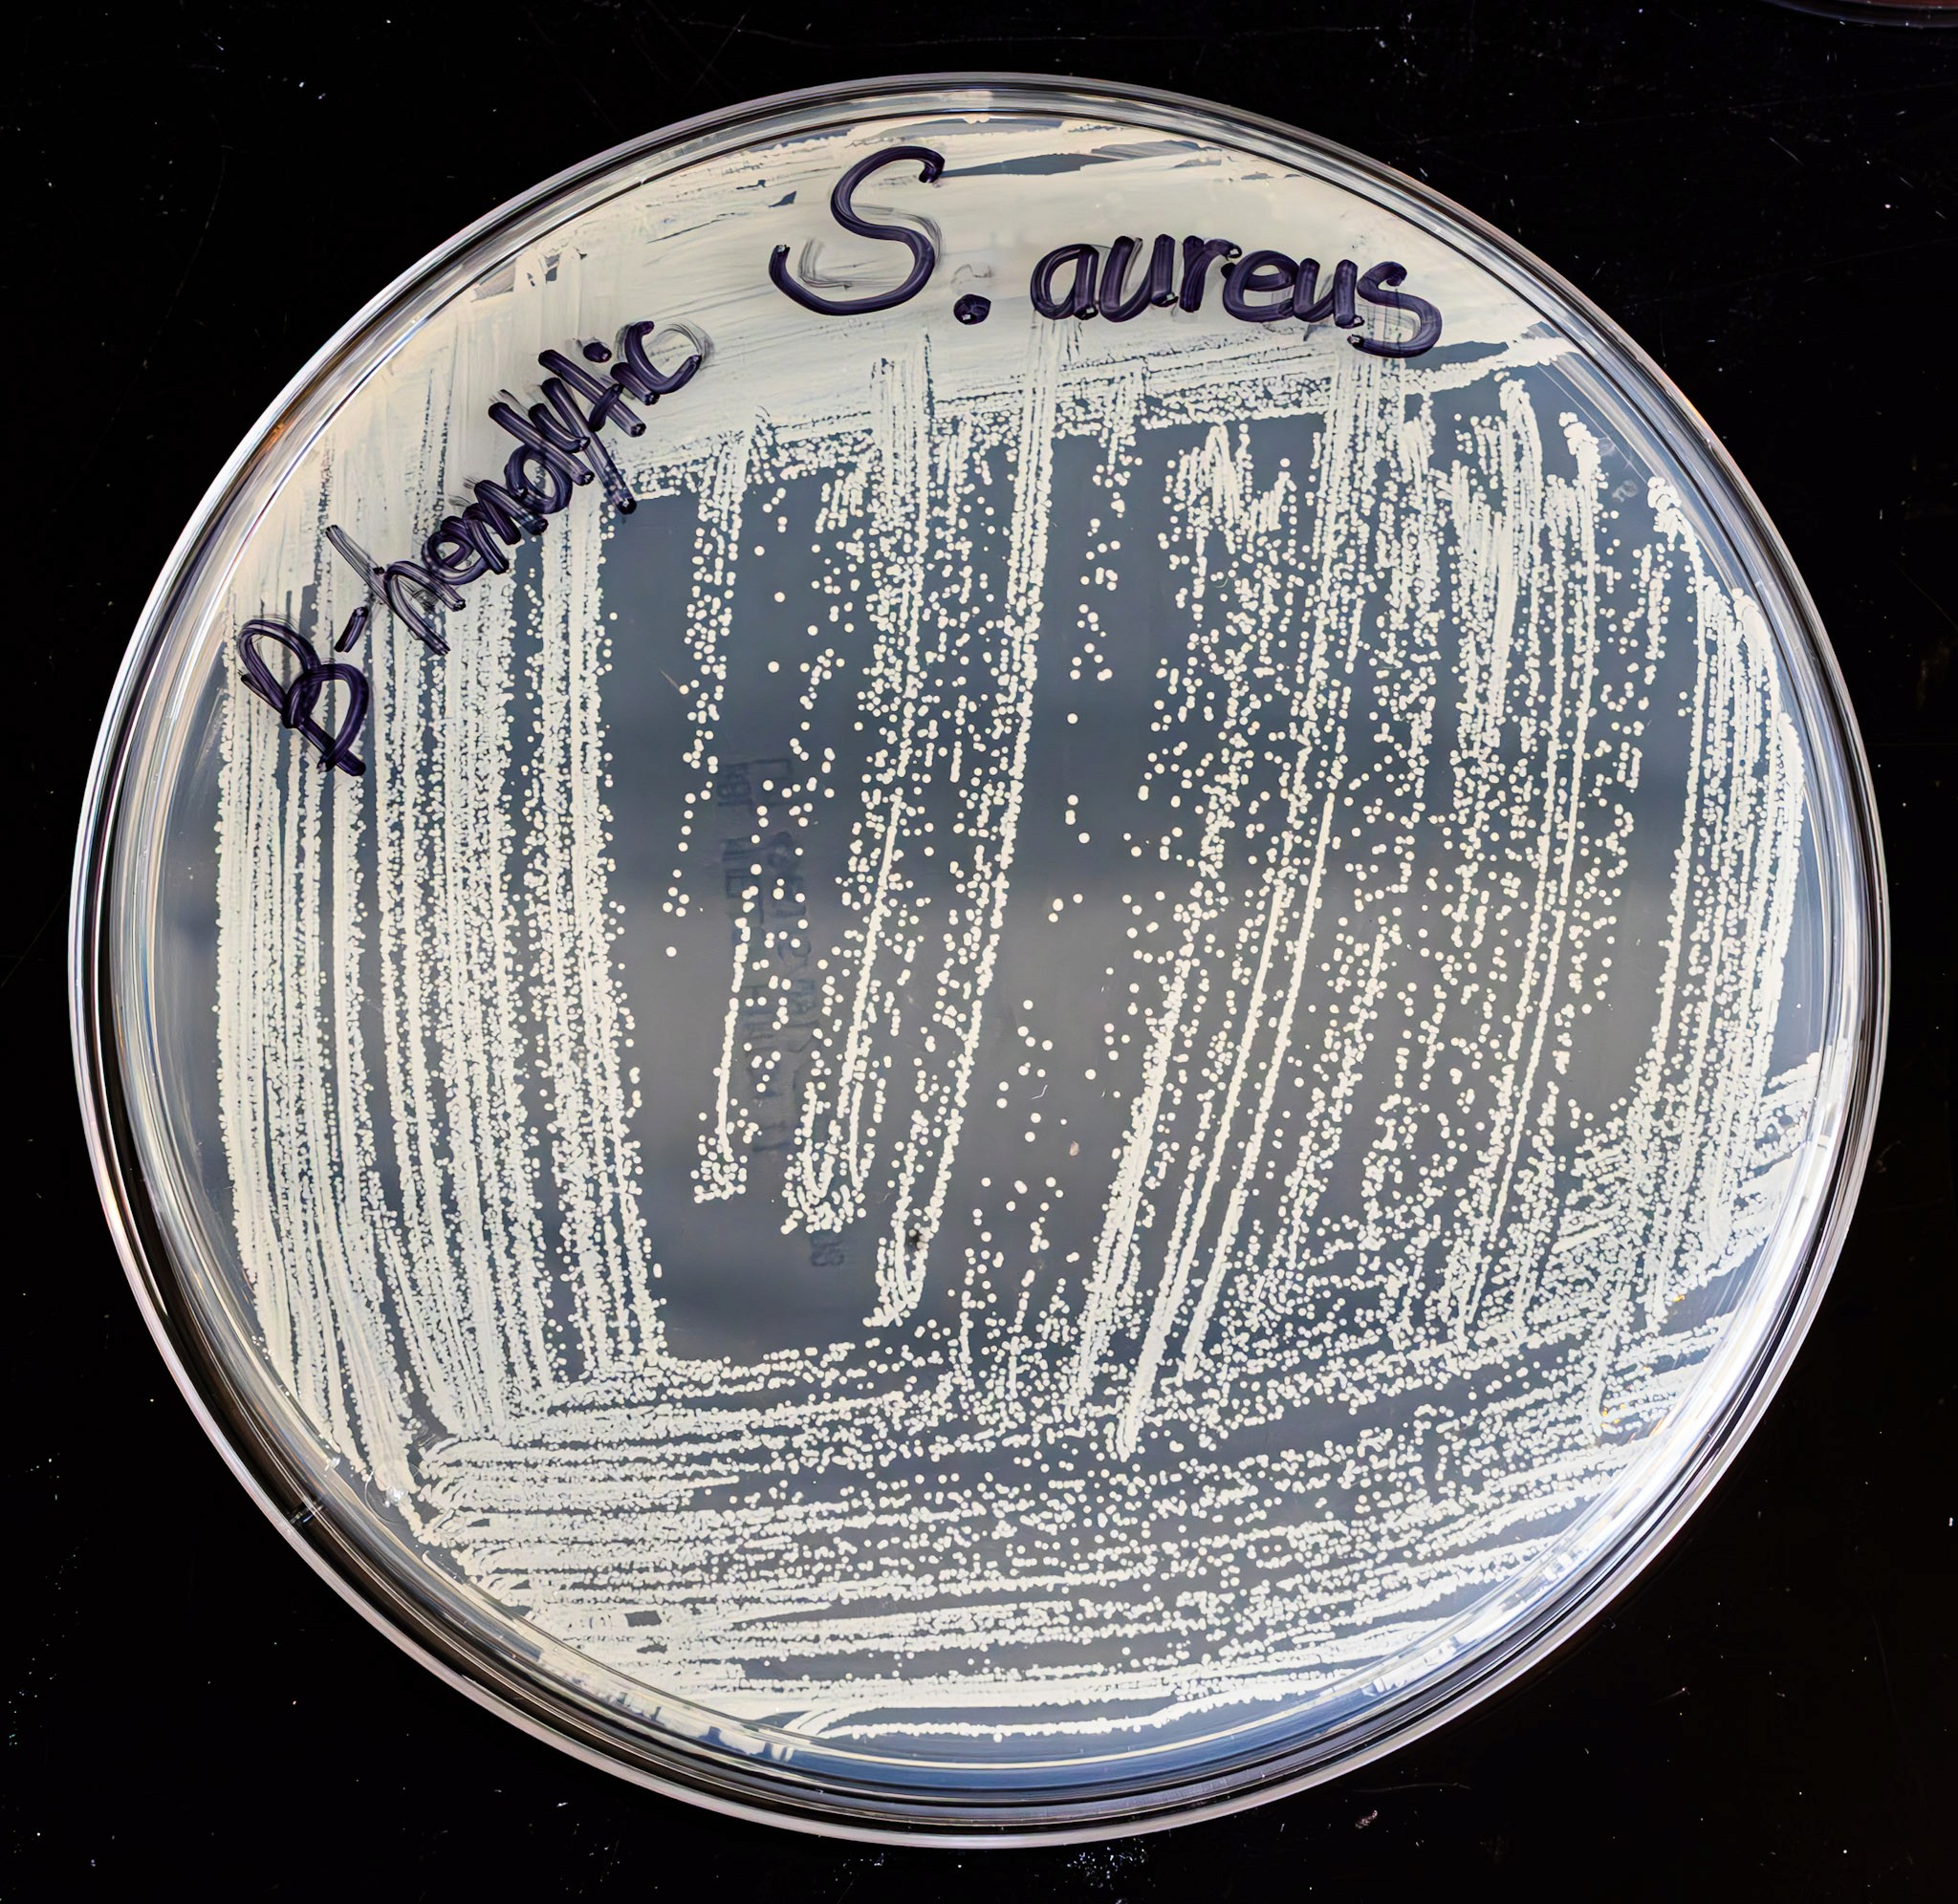
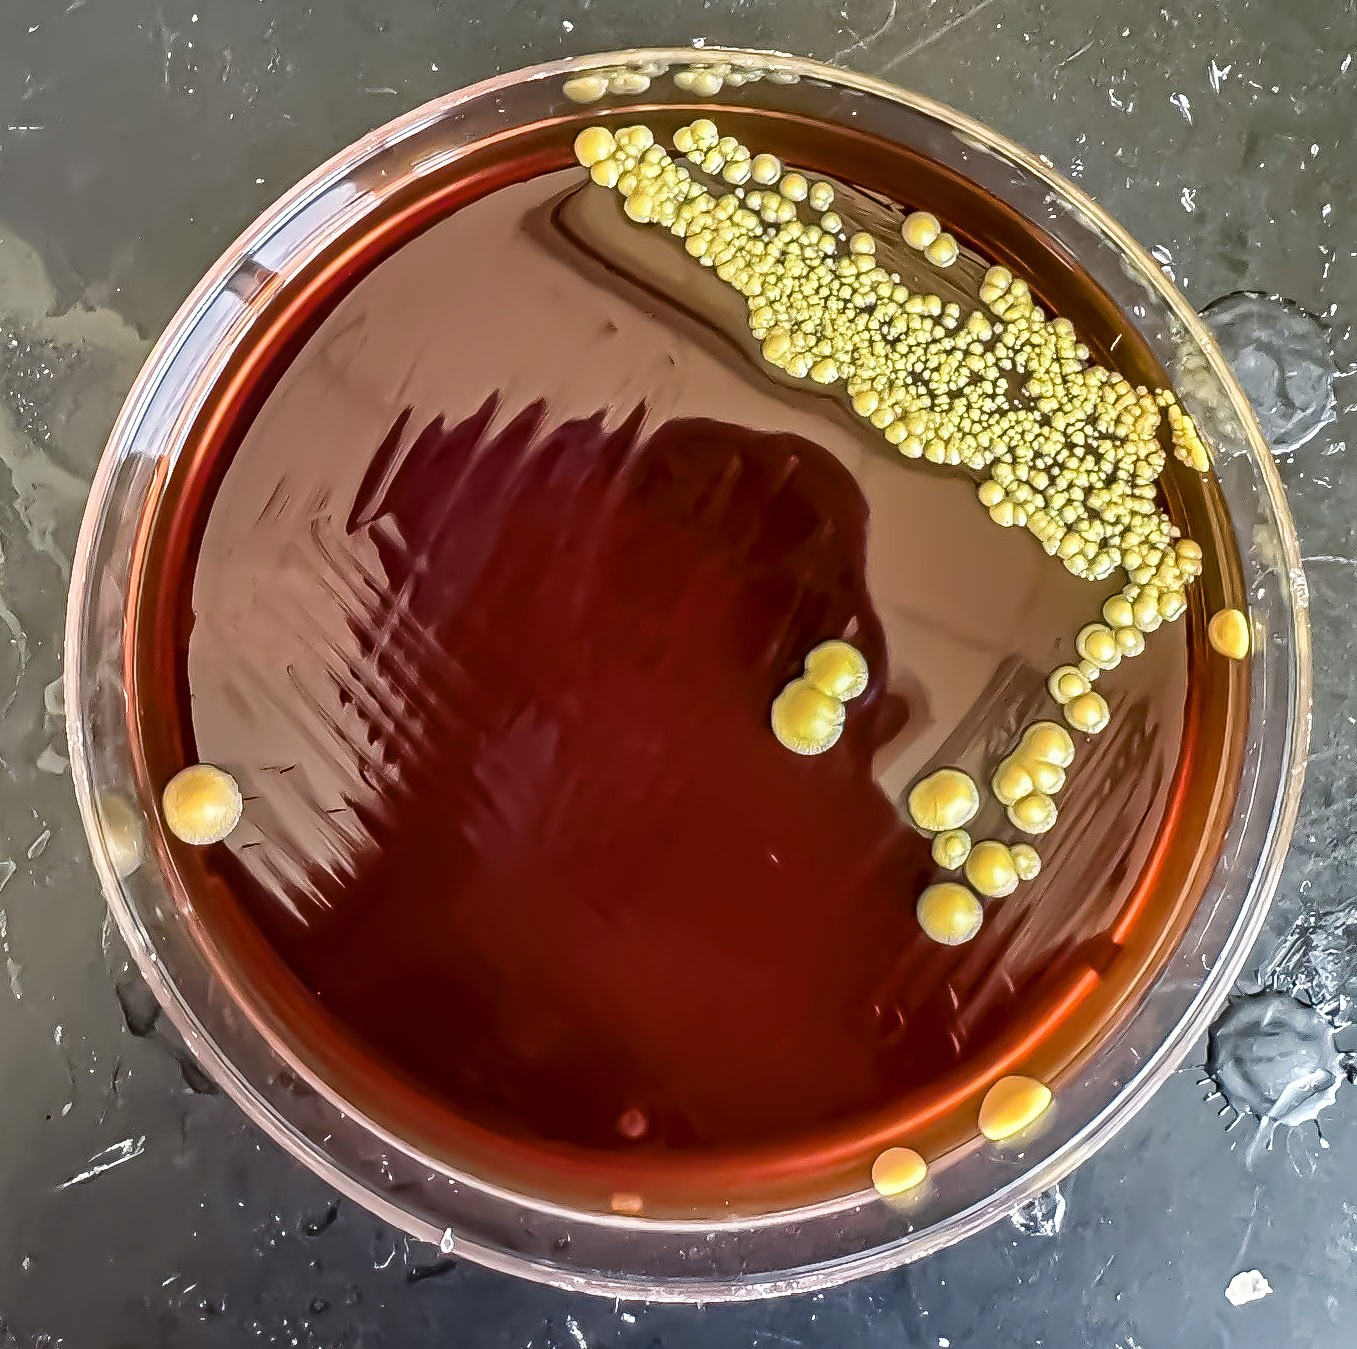

About Kasey Portanova
Medical Illustrator
Graphic Designer
Fine Artist
Behind the Scenes
This project was heavily inspired by my studies in Clinical Microbiology during my final semester at RIT. Taking this course alongside my capstone allowed me to directly apply what I was learning about bacterial morphology, colony growth, and disease characteristics into my illustrations and models.
I studied real-world examples of bacterial colonies on agar plates, focusing on identifying traits like color, size, texture, spreading patterns, and hemolysis reactions.
Please explore the gallery below to see photos I captured in Professor Osgood's Clinical Microbiology lab. These images document the different agar plates and bacterial colonies I worked with during the course, along with some extras!